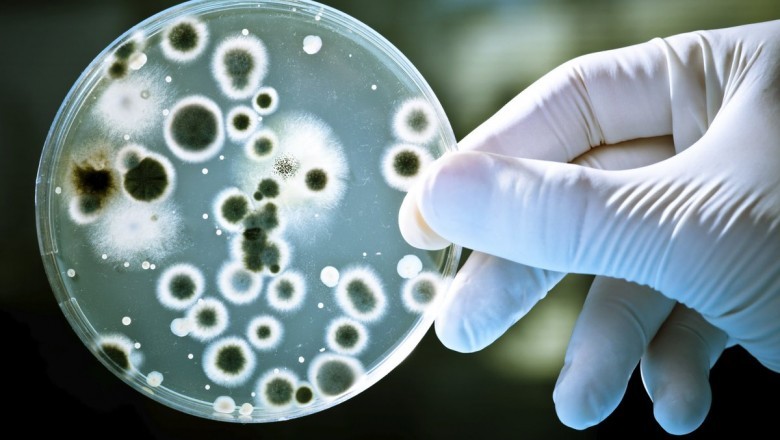
Mold Remediation Glenside

129
views
views
Our level of expertise and detail tour work is unmatched, hence the reason that we are the highest rated mold removal company on every major website and search engine around.
Our level of expertise and detail tour work is unmatched, hence the reason that we are the highest rated mold removal company on every major website and search engine around. You can trust that when you hire us for your mold remediation project, we will get the job done right, the first time. There are a lot of mold companies claiming to be the best, but there’s only one that can prove it. Mold Remediation Glenside












